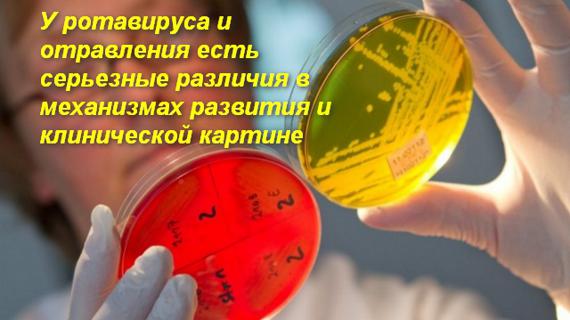
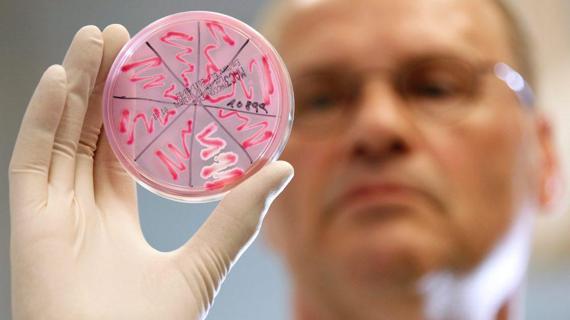

Белок в моче после ротавируса
Особенно часто кишечным гриппом болеют дети первых двух лет жизни, и к возрасту 5 лет около 95% детей переносят ротавирусную инфекцию. Пик заболеваемости приходится на холодный период года в зимне-весенние месяцы...
 6i5z
6i5z 
 6i5z
6i5z 
 6i5z
6i5z 
 6i5z
6i5z 


 Сайт о паразитах
Сайт о паразитах
Отравление.ру
Отравление.ру 

 Отравления Инфо
Отравления Инфо 
 О младенцах
О младенцах 

 Мед. cовет
Мед. cовет 



 Простуда и грипп
Простуда и грипп  Коронавирус
Коронавирус  Гастроэнтерология
Гастроэнтерология  Заболевания легких и дыхательных путей
Заболевания легких и дыхательных путей  Заболевания печени
Заболевания печени  Заболевания горла
Заболевания горла  Заболевания вен и сосудов
Заболевания вен и сосудов  Аллергология
Аллергология  Грибковые заболевания
Грибковые заболевания  Женские заболевания
Женские заболевания  Проктология
Проктология  Кожные заболевания
Кожные заболевания  Педиатрия
Педиатрия  Заболевания суставов и костей
Заболевания суставов и костей  Заболевания спины и позвоночника
Заболевания спины и позвоночника  Беременность и роды
Беременность и роды  Заболевания сердца
Заболевания сердца  Маммология
Маммология  Онкология
Онкология  Заболевания крови
Заболевания крови  Заболевания глаз
Заболевания глаз  Красота
Красота  Диеты и здоровое питание
Диеты и здоровое питание  Заболевания ушей
Заболевания ушей  Стоматология
Стоматология  Наркология
Наркология  Косметология
Косметология  Психиатрия
Психиатрия  Сексология
Сексология  Анализы и диагностика
Анализы и диагностика  Хирургия
Хирургия  Заболевания щитовидной железы
Заболевания щитовидной железы 








 Лечение заболеваний
Лечение заболеваний